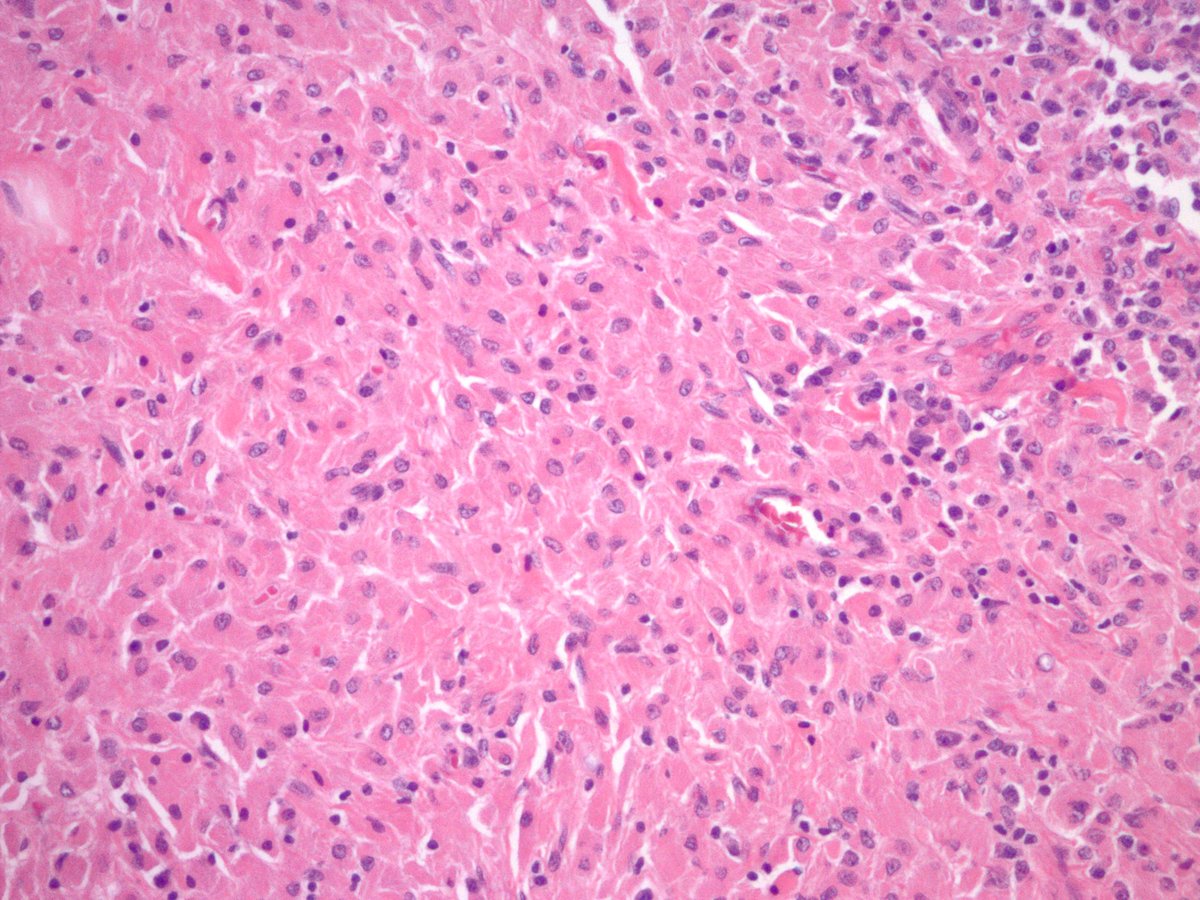
jake_bledsoe's tweet image. CRYSTAL STORING HISTIOCYTOSIS in a lymph node. Macrophages laden with eosinophilic subtle crystalline material. CD68 and kappa IHC shown. Lambda was negative. #pathology #hemepath #BSTpath

UMass Path
@UMassPath
UMass Pathology Residency
You might like
For trainees->nice exp of collagen ball in a pelvic wash sample. Not to be confused with adenoca (which may be seen as 3D structures w community borders). Collagen balls r seen in up to half of pelvic washings & r spherical masses of collagen lined by mesothelial cells #CytoPath


Some follicular lymphomas may appear to be BCL2-negative with commonly used IHC antibodies. Some of these cases have mutations in BCL2 that impact protein detection. Alternate BCL2 clones may be useful, as in this case. onlinelibrary.wiley.com/doi/full/10.10… #pathology #hemepath




Oh Boy! This is a stunner. Pancreatic tumor. Youngish person. Diffusely keratin positive. Was called a poorly differentiated carcinoma. Sounds reasonable? #GIpath




Andrew H. Fischer, MD, candidate for ASC Executive Board Medical Member answers the question, What do you see happening in your current work environment that may have an effect on the cytopathology community? buff.ly/3bmX5fi

A very photogenic tumor 😊 Chondrosarcoma (L) ot the cricoid cartilage (R).

Appendix with lupus vasculitis. Appendectomy for presumed appendicitis. No acute appendicitis seen. Vessels within and outside of the appendix showed these changes with focal fibrinoid necrosis. Clinically and serologically active SLE. #GIpath #pathology




Meckel's diverticulum with pancreatic and gastric heterotopia. #GIpath #pathology



CAP (@Pathologists) is launching Virtual Live Lectures for pathology residents! Join us every weekday at 10am CT for expert lectures. Series kicks off tomorrow, 4/1, w/ @bjmagnani titled "Tik Tox". Learn more: capatholo.gy/virtual-lectur… #pathresidency

Kudos to all the Path educators, who are continuing teaching in these uncertain times! What do you think these beautiful (hint: rosette-like) organisms are? #microbiology #pathology

Senior residents: Myself and others serve on @TheABPath Resident and Fellow Advisory Committee. We will be discussing the current situation on Thursday directly with Dr. Johnson. DM me your concerns and I will anonymously communicate them on the call. #pathboards

As residency programs begin to adopt #RemoteLearning initiatives, we hope you will find our digital slide repository valuable. Hundreds of annotated cases across a wide range of diagnostic entities: learn.mghpathology.org/index.php/Stud…




Congratulations to our incoming class of path residents! We are very excited to work with you. Happy #MatchDay2020 to everyone!

We have an unexpected opening for the 2020-2021 GU Pathology Fellowship position at the University of Chicago Medical Center. Please pass this information. #Pathology #PathologyResidents #PathologyFellowship #GUPath

Biopsy of an incidentally discovered 5 cm well-circumscribed retroperitoneal mass abutting the bladder in a middle aged adult. Does anyone want to hazard a guess before I show the IHC? #BSTpath #pathology




CRYSTAL STORING HISTIOCYTOSIS in a lymph node. Macrophages laden with eosinophilic subtle crystalline material. CD68 and kappa IHC shown. Lambda was negative. #pathology #hemepath #BSTpath

United States Trends
- 1. 1.3 SOL N/A
- 2. Good Friday N/A
- 3. #FanCashDropPromotion N/A
- 4. #สนามอ่านเล่น2026xJimmySea N/A
- 5. JS AVOCEAN FAM SIGN N/A
- 6. #FridayVibes N/A
- 7. #ราคีTHESTAIN N/A
- 8. Happy Friyay N/A
- 9. #FridayMotivation N/A
- 10. RED Friday N/A
- 11. MEET DAY N/A
- 12. Hire Americans N/A
- 13. Christ Jesus N/A
- 14. Autopilot N/A
- 15. Cudi N/A
- 16. Ari Lennox N/A
- 17. Robbo N/A
- 18. March for Life N/A
- 19. TACC N/A
- 20. Inside the NBA N/A
You might like
-
 UW Pathology Res and Fel
UW Pathology Res and Fel
@UWLMPathRes -
 UMMC Pathology
UMMC Pathology
@UMMC_Pathology -
 Cleveland Clinic Pathology Residency
Cleveland Clinic Pathology Residency
@CCFPathRes -
 DukePathDept
DukePathDept
@DukePathDept -
 UVA Pathology
UVA Pathology
@UVA_Pathology -
 UNM Pathology
UNM Pathology
@UNMPathology -
 Geisinger Pathology
Geisinger Pathology
@GeisingerPath -
 University of Iowa Pathology
University of Iowa Pathology
@UIPathology -
 UPMC Pathology Residency Program
UPMC Pathology Residency Program
@UPMCPath -
 Dartmouth Health Pathology Residency
Dartmouth Health Pathology Residency
@DHPathRes -
 BSW Temple Pathology Residency
BSW Temple Pathology Residency
@BSWHTemple_PATH -
 UofLPathology
UofLPathology
@l_pathology -
 UTSW Department of Pathology
UTSW Department of Pathology
@UTSW_Pathology
Something went wrong.
Something went wrong.



































































































































